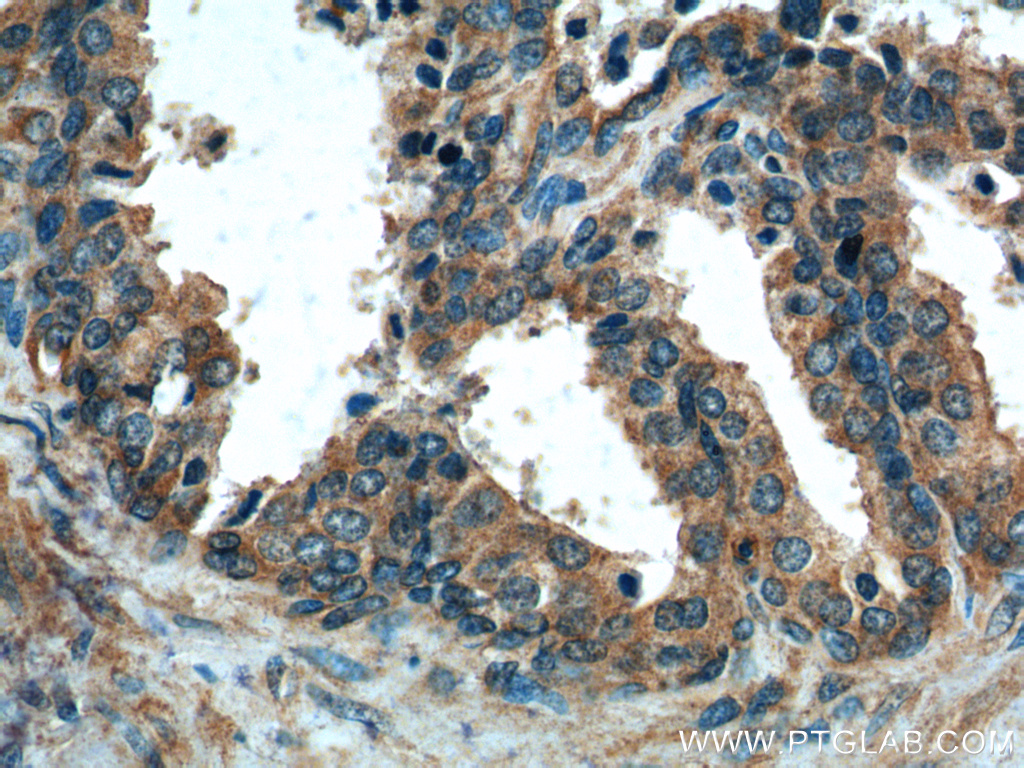

验证数据展示
经过测试的应用
| Positive WB detected in | HeLa cells, Transfected HEK-293 cells |
| Positive IP detected in | HeLa cells |
| Positive IHC detected in | human prostate cancer tissue, human prostate hyperplasia tissue Note: suggested antigen retrieval with TE buffer pH 9.0; (*) Alternatively, antigen retrieval may be performed with citrate buffer pH 6.0 |
| Positive IF/ICC detected in | A431 cells |
| Positive FC (Intra) detected in | HeLa cells |
推荐稀释比
| 应用 | 推荐稀释比 |
|---|---|
| Western Blot (WB) | WB : 1:500-1:1000 |
| Immunoprecipitation (IP) | IP : 0.5-4.0 ug for 1.0-3.0 mg of total protein lysate |
| Immunohistochemistry (IHC) | IHC : 1:50-1:500 |
| Immunofluorescence (IF)/ICC | IF/ICC : 1:50-1:500 |
| Flow Cytometry (FC) (INTRA) | FC (INTRA) : 0.40 ug per 10^6 cells in a 100 µl suspension |
| It is recommended that this reagent should be titrated in each testing system to obtain optimal results. | |
| Sample-dependent, Check data in validation data gallery. | |
产品信息
15176-1-AP targets Gamma Tubulin in WB, IHC, IF/ICC, FC (Intra), IP, ELISA applications and shows reactivity with human, mouse, rat, canine samples.
| 经测试应用 | WB, IHC, IF/ICC, FC (Intra), IP, ELISA Application Description |
| 文献引用应用 | WB, IHC, IF |
| 经测试反应性 | human, mouse, rat, canine |
| 文献引用反应性 | human, mouse |
| 免疫原 |
CatNo: Ag7070 Product name: Recombinant human tubulin-gamma protein Source: e coli.-derived, PGEX-4T Tag: GST Domain: 103-451 aa of BC000619 Sequence: NWASGFSQGEKIHEDIFDIIDREADGSDSLEGFVLCHSIAGGTGSGLGSYLLERLNDRYPKKLVQTYSVFPNQDEMSDVVVQPYNSLLTLKRLTQNADCVVVLDNTALNRIATDRLHIQNPSFSQINQLVSTIMSASTTTLRYPGYMNNDLIGLIASLIPTPRLHFLMTGYTPLTTDQSVASVRKTTVLDVMRRLLQPKNVMVSTGRDRQTNHCYIAILNIIQGEVDPTQVHKSLQRIRERKLANFIPWGPASIQVALSRKSPYLPSAHRVSGLMMANHTSISSLFERTCRQYDKLRKREAFLEQFRKEDMFKDNFDEMDTSREIVQQLIDEYHAATRPDYISWGTQEQ 种属同源性预测 |
| 宿主/亚型 | Rabbit / IgG |
| 抗体类别 | Polyclonal |
| 产品类型 | Antibody |
| 全称 | tubulin, gamma 1 |
| 别名 | TUBG1, Gamma-1-tubulin, Gamma-tubulin complex component 1, GCP-1, TUBG |
| 计算分子量 | 51 kDa |
| 观测分子量 | 50-55 kDa |
| GenBank蛋白编号 | BC000619 |
| 基因名称 | Gamma Tubulin |
| Gene ID (NCBI) | 7283 |
| RRID | AB_2878113 |
| 偶联类型 | Unconjugated |
| 形式 | Liquid |
| 纯化方式 | Antigen affinity purification |
| UNIPROT ID | P23258 |
| 储存缓冲液 | PBS with 0.02% sodium azide and 50% glycerol, pH 7.3. |
| 储存条件 | Store at -20°C. Stable for one year after shipment. Aliquoting is unnecessary for -20oC storage. |
背景介绍
Gamma tubulin is a member of tubulin superfamily and is a key component required for microtubule nucleation and stabilization. It is concentrated at the pericentriolar material of centrosomes in interphase cells, predominantly on spindle poles in mitotic cells, while found in midbodies during cytokinesis. Overexpression of gamma tubulin has been found in various cancers including breast cancer and gliomas. This antibody can well label the centrosome structure.
实验方案
| Product Specific Protocols | |
|---|---|
| FC protocol for Gamma Tubulin antibody 15176-1-AP | Download protocol |
| IF protocol for Gamma Tubulin antibody 15176-1-AP | Download protocol |
| IHC protocol for Gamma Tubulin antibody 15176-1-AP | Download protocol |
| IP protocol for Gamma Tubulin antibody 15176-1-AP | Download protocol |
| WB protocol for Gamma Tubulin antibody 15176-1-AP | Download protocol |
| Standard Protocols | |
|---|---|
| Click here to view our Standard Protocols |
发表文章
| Species | Application | Title |
|---|---|---|
Nat Commun INTS13 variants causing a recessive developmental ciliopathy disrupt assembly of the Integrator complex | ||
PLoS Biol Noncoding RNA Ginir functions as an oncogene by associating with centrosomal proteins. | ||
Cell Death Differ Haploinsufficiency of GCP4 induces autophagy and leads to photoreceptor degeneration due to defective spindle assembly in retina. | ||
Br J Pharmacol NL13, a novel curcumin analogue and polo like kinase 4 inhibitor, induces cell cycle arrest and apoptosis in prostate cancer models | ||
Elife LUZP1, a novel regulator of primary cilia and the actin cytoskeleton, is a contributing factor in Townes-Brocks Syndrome. |